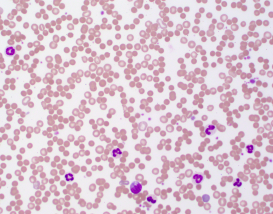
Blood smear

Current Projects

Tick antiserum is the mainstay therapy used by veterinarians to treat cats affected by the paralysis tick Ixodes holocyclus. However it is not without risk of acute anaphylaxis associated with administration of the currently available canine-derived tick antiserum. This project is investigating the effect of chromatographic purification on canine tick antiserum to produce a highly refined immunoglobulin product. Tick antiserum contains all the proteins found in normal dog serum, including albumin. It is hypothesised that anti-albumin IgE may be produced in cats following tick antiserum treatment and this may sensitise cats to acute anaphylaxis if subsequently administered. Removal of albumin and other unnecessary proteins may lead to less adverse reactions and improve the standard of care that can be offered by veterinarians. This project is a collaborative effort supported by Boehringer Ingleheim Animal Health Australia, Padula Serums and cooperating veterinarians.
Snake Venom Detection

Snakebite in animals can present in varying clinical presentation and development of new and improved rapid diagnostic tests is needed for the veterinary profession. Padula Serums is actively working on developing a new venom detection system designed specifically for the veterinary profession. Watch this space!
Improving Tick Paralysis Treatment & Diagnosis

The Australian paralysis tick (Ixodes holocyclus) continues to be a major health hazard for dogs and cats. Diagnosis of tick paralysis can be challenging in animals presenting with signs of lower motor neurone paralysis but no tick present. Treatment of cats continues to be a problem in terms of reactions to canine derived tick antiserum. Further research is required to improve diagnostic tools and treatments.
Understanding Copperhead Envenomations

The lowland copperhead snake (Austrelaps superbus) is found in many areas of south eastern Australia but very little information has been published on the envenomation syndrome in dogs and cats. Whilst envenomation of dogs and cats appears to be infrequent the outcome can be fatal. The venom is known to contain a range of toxins including neurotoxins, myotoxins and anticoagulants. Padula Serums is keen to engage with veterinary practices that are located in geographic regions where the snake species occur to better understand the envenomation syndrome.
Minimising Complications After Red-Bellied Black Snakebite
The red-bellied black snake (Pseudechis porphyriacus) is a common cause of snakebite in dogs and cats in the eastern states of Australia. Although the venom is noticeably less lethal than that from tiger and brown snakes complications can occur following treatment. These complications include neurotoxicity, haematological abnormalities including anemia and spherocytosis and severe tissue necrosis at the bite site. Further research is being undertaken to improve treatment outcomes and minimise complications of snakebite by this species.
